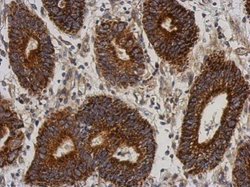

Promotional price valid on web orders only. Your contract pricing may differ. Interested in signing up for a dedicated account number?
Learn More
Learn More
Invitrogen™ C21orf2 Polyclonal Antibody


Rabbit Polyclonal Antibody
Supplier: Invitrogen™ PA531331
Description
Recommended positive controls: 293T, A431, Jurkat, Raji. Store product as a concentrated solution. Centrifuge briefly prior to opening the vial.
Four alternatively spliced transcript variants encoding four different isoforms have been found for this nuclear gene. All isoforms contain leucine-rich repeats. Three of these isoforms are mitochondrial proteins and one of them lacks the target peptide, so is not located in mitochondrion. This gene is down-regulated in Down syndrome (DS) brain, which may represent mitochondrial dysfunction in DS patients.
Specifications
| C21orf2 | |
| Polyclonal | |
| Unconjugated | |
| CFAP410 | |
| C21orf2; C21orf-HUMF09G8.5; cDNA A2-YF5; CFAP410; chromosome 21 open reading frame 2; Cilia- and flagella-associated protein 410; cu002; leucine rich repeat containing 76; leucine-rich repeat-containing protein 76; LRRC76; nuclear encoded mitochondrial protein C21orf2; protein C21orf2; YF5; YF5/A2 | |
| Rabbit | |
| Antigen affinity chromatography | |
| RUO | |
| 755 | |
| Store at 4°C short term. For long term storage, store at -20°C, avoiding freeze/thaw cycles. | |
| Liquid |
| Immunohistochemistry (Paraffin), Western Blot, Immunocytochemistry | |
| 0.72 mg/mL | |
| 0.1M tris glycine with 20% glycerol and 0.01% thimerosal; pH 7 | |
| O43822 | |
| CFAP410 | |
| Recombinant protein encompassing a sequence within the center region of human C21orf2. The exact sequence is proprietary. | |
| 100 μL | |
| Primary | |
| Human | |
| Antibody | |
| IgG |
Safety and Handling
WARNING: Cancer - www.P65Warnings.ca.gov
Product Content Correction
Your input is important to us. Please complete this form to provide feedback related to the content on this product.
Product Title
Spot an opportunity for improvement?Share a Content Correction